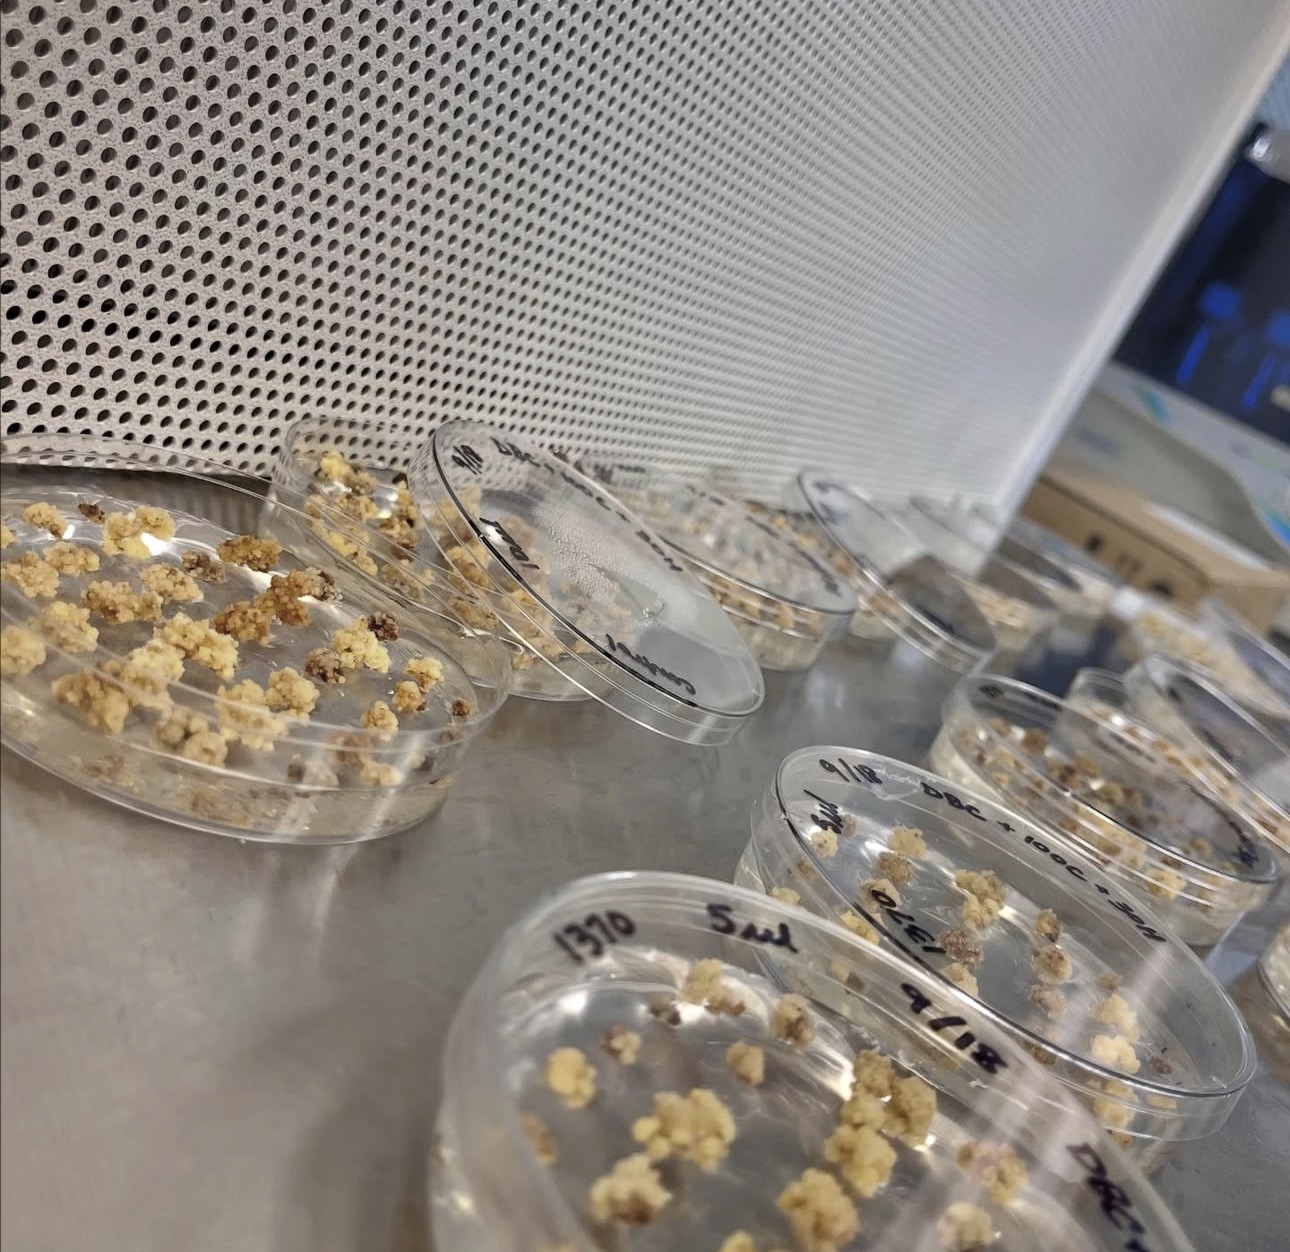

1. Plant Micropropagation
We specialize in producing high-quality, uniform, and disease-free plant material through advanced micropropagation techniques. Our optimized protocols enable rapid multiplication of elite genotypes, ensuring consistency, vigor, and year-round availability.
What you get:
.jpg)

2. Tissue Culture Protocol Development
We design, validate, and optimize tailored tissue culture protocols for commercial crops and medicinal plants. From callus induction to rooting, we help you accelerate R&D and reduce production costs.
We work on:

3. Genetic Resource Preservation
We offer secure, long-term in vitro conservation services to safeguard valuable genetic resources.
Benefits:

4. Secondary Metabolite Production
We use plant biotechnology strategies to enhance the production of high-value secondary metabolites in controlled environments.
Applications:
5. Scaling for Commercial Production
We help startups and agribusinesses transition from lab-scale experiments to commercial-scale production systems.
Our support includes:
6. Industry Collaboration & R&D Support
Whether you’re developing a new cultivar or launching a biotech product, our team provides research partnerships and technical expertise to accelerate innovation.
We collaborate with:
